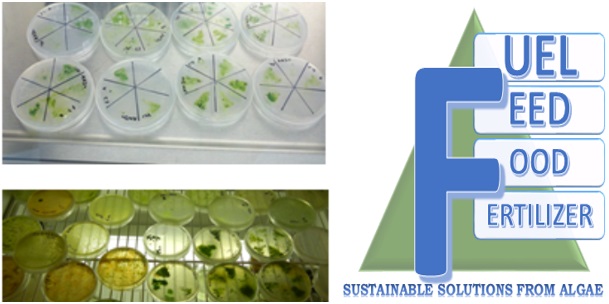

Effective Date: September 1, 2023
Welcome to www.newtrient.com, a website operated by Newtrient, LLC ("Newtrient," "us" or "we"). This Privacy Policy and Terms of Use ("Terms") describe the terms and conditions on which Newtrient offers you access to this website and other websites and electronic services to which these Terms are linked (collectively, "online services"). Read these Terms carefully, as they constitute a legal agreement between Newtrient and you.
IMPORTANT NOTE: These Terms contain provisions that limit our liability to you and require you to resolve any dispute with us through final and binding arbitration on an individual basis and not as part of any class or representative action. Please see "Disclaimers," "Limitations of Liability" and "Dispute Resolution" below for more information.
If you do not agree to any of these Terms, please do not use Newtrient’s online services.
Privacy Policy
We respect your privacy and aim to protect your personal data. We have adopted this portion of our Terms – our online Privacy Policy – to explain what information may be collected through our online services, how we use this information, and under what circumstances we may disclose the information to third parties. This Privacy Policy applies only to information we collect through our online services and does not apply to our collection of information from other sources.
Collection of Personal Data
When you use our online services, we may collect two kinds of information about you: personal data and non-personal data.
"Personal data," when used in these Terms, refers to information that can be used to personally identify you, such as your name, e-mail address or mailing address. As a general policy, we do not automatically or without you knowingly providing it, collect your personal data when you visit the online services.
"Non-personal data" means information that does not and cannot be used to personally identify you. Examples of non-personal data include IP addresses, the type of browser you are using, the third party website from which your visit originated, the operating system you are using, the domain name of your Internet service provider, the search terms you use on the online services, the specific web pages you visit, and the duration of your visits. Non-personal data can also include certain de-identified personal data or aggregated personal data; that is, information that has been rendered anonymous.
Most of Newtrient’s online services do not require you to submit any personal data, so you may visit Newtrient.com or use other of our online services without revealing who you are. However, some services may require registration or other user interaction. In certain circumstances, we may provide you with an opportunity to submit your personal data in connection with a feature, program, promotion or some other aspect of our online services. For instance, you may: (a) provide certain personal data, such as your name and email address, if you want to access Newtrient’s Technology Catalog; (b) provide certain demographic information (e.g., age, gender, purchase preference, usage frequency, etc.) when you participate in a survey or poll, join a group, seek additional information from us, or sign up for a newsletter; or (c) post a general comment and/or recommendation on our online services. Whether you provide your personal data is your choice; however, your personal data may be required to participate in a particular activity or gain access to or use certain parts of Newtrient.com or other online services as intended.
Third parties that assist us with our business operations may also collect and use information (including personal data and non-personal data) through Newtrient.com and other online services and also may share the collected information with us. For example, our internet support vendors collect and share information with us to analyze use of Newtrient.com and other online services, to help us detect and prevent fraud and to improve user experience.
We obtain non-personal data about you from information that you provide us, either separately or together with your personal data. We also may use data collection technology to help us automatically collect certain non-personal data from you when you access our online services. For more information about our use of data collection technology, please see our "Automatic Data Collection, Cookies and Do Not Track Signals" section below.
The information you disclose and provide through Newtrient.com or other interactive online services may be linked (subject to all applicable laws) with the personal data provided elsewhere in or through Newtrient.com or other services or of that received from third parties.
User Generated Content. We collect information that you voluntarily provide as part of our online services, including posts, comments, reviews, and product ratings you submit (together, "User Generated Content"). Newtrient may, in our sole discretion, publicly post or otherwise share your User Generated Content with others. If you do not want personal data or other information shared with others, you should not submit User Generated Content, or should not submit User Generated Content that contains the information you do not want shared in this manner. Once you have submitted User Generated Content, we reserve the right to publish it in any medium to others.
Intended Use of Personal Data
The personal data you submit to us is generally used to carry out your requests, respond to your inquiries, better serve you, or in other ways naturally associated with the circumstances in which you provided the information. We may also use your personal data to later contact you for a variety of reasons, including, without limitation, to:
provide you with customer service
improve the online services
send marketing and other promotional information to you
communicate with you about content or other information you have posted or shared with us through our online services
verify the legitimacy of reviews and ratings
notify you about updates to the online services
carry out other purposes that are disclosed to you and to which you consent
We use non-personal data in a variety of ways, including to help us analyze site traffic, understand customer needs and trends, carry out targeted promotional activities, analyze the marketplace for resource recovery products, and to improve our online services. We may share your non-personal data with third parties to achieve these objectives and for other purposes.
We may combine your personal data and non-personal data with others’ personal data and non-personal data to create summary data and aggregate data that we may use for our business purposes, such as research to improve our products and analyses that may help us better market our products. Such summary and aggregate data is non-personal data because it does not personally identify you or any other specific individual.
Out of Marketing Emails: You may opt-out from receiving marketing and other promotional information from us by clicking the unsubscribe link included in each marketing email, or by emailing us at
[email protected] to notify us of your preferences.
Access and Modification Requests: If you need to access or modify the personal data we have collected about you, please contact us at
[email protected] with your request.
Disclosure of Personal Data
We may disclose your personal data in the following circumstances:
Upon your Request. We may disclose your personal data to a third party with whom you request that we share your data.
Service Providers. We may share your personal data with our third party vendors which we engage to perform functions on our behalf – e.g., administer our promotions, provide us marketing or promotional assistance, analyze our data, and assist us with customer service.
Corporate Transaction. We may share and transfer personal data if we are involved in a merger, sale, acquisition, divestiture, restructuring, reorganization, dissolution, bankruptcy or other change of ownership or control (in each case, whether in whole or in part).
As Required or Permitted by Law. Notwithstanding anything herein to the contrary, we reserve the right to disclose your personal data (i) as permitted by law; (ii) if we determine that disclosure of specific information is necessary to comply with the request of a law enforcement or regulatory agency or other legal process; (iii) to protect the rights, privacy, property, interests or safety of our company or our affiliates, customers, business partners, employees or the general public; (iv) to pursue available remedies or limit the damages; (v) to enforce our Terms of Use; and (vi) to respond to an emergency.
Automatic Data Collections, "Cookies" and "Do Not Track" Signals
As discussed above, Newtrient automatically collects non-personal data through our use of cookies, pixel tags (also known as web beacons and clear GIFs) and other similar technology (together, "data collection technology").
A cookie is a small data file transferred by a website to your computer's hard drive. Cookies are not intended to damage your computer and cannot be used to run programs or deliver viruses. The cookies used by the online services do not allow access to users' personal data, but may be used to identify individual computers, allow us to estimate and report site traffic and to help improve the contents of the online services. You have the ability to accept or decline cookies by modifying the settings of your Web browser. If you choose to decline cookies, you may not be able to fully experience the interactive features of the online services or other websites you visit.
Some web browsers incorporate a "do-not-track" ("DNT") or similar feature that signals to websites with which the browser communicates that a visitor does not want to have his/her online activity tracked. If a digital service that responds to a particular DNT signal receives the DNT signal, the browser can block that digital service from collecting certain information about the browser’s user. Not all browsers offer a DNT option and DNT signals are not yet uniform. For this reason, Newtrient along with many other digital service operators do not currently respond to DNT signals. For more information about DNT signals, visit allaboutdnt.com.
Google Analytics. We may use a tool called "Google Analytics" to collect information about use of our online services. Google Analytics collects information such as how often users visit this site, what pages they visit when they do so, and what other sites they used prior to coming to this site. We use the information we get from Google Analytics only to improve our online services. Google Analytics collects only the IP address assigned to you on the date you visit our online services, rather than your name or other identifying information. We do not combine the information collected through the use of Google Analytics with personal data. Although Google Analytics plants a permanent cookie on your web browser to identify you as a unique user the next time you visit this site, the cookie cannot be used by anyone but Google. Google’s ability to use and share information collected by Google Analytics about your visits to this site is restricted by the Google Analytics Terms of Use and the Google Privacy Policy. You can prevent Google Analytics from recognizing you on return visits to this site by disabling cookies on your browser.
California Privacy Rights
Under California Civil Code Section 1798.83, Newtrient is required, once per calendar year and upon request, to disclose to customers that are California residents the identity of any third parties to whom the business has disclosed personal data within the previous calendar year, along with the type of personal data disclosed, for the third parties’ direct marketing purposes. Newtrient does not disclose personal data to any third parties for their direct marketing purposes.
If you are a California resident under age 18, then you may request that we remove any user contribution that you publicly posted on the online services. We will make a good faith effort to delete or remove your user contribution from public view as soon as reasonably practicable; however, we may be required by law to not remove or allow removal of your user contribution. To request removal of your user contribution, please send an email with a detailed description of your specific user contribution to
[email protected]. Newtrient reserves the right to request that you provide information that will enable us to confirm the user contribution you want removed was created and posted by you.
Personal Data and Children
Newtrient’s online services are not intended for children. Newtrient does not knowingly collect, use or disclose personal data from a minor under the age of 13 through the online services without obtaining consent from a person with parental responsibility (i.e., a parent or guardian). Newtrient will provide the parent with (i) notice of the specific types of personal data being collected from the minor, and (ii) the opportunity to object to any further collection, use, or storage of such information. Newtrient abides by the Children's Online Privacy Protection Act in the United States.
Links to Other Sites
These Terms apply only to Newtrient.com and Newtrient’s other online services and do not apply to third-party websites not operated by Newtrient. Newtrient’s online services may include links to other websites that Newtrient believes may be of interest to its visitors. A link to a third-party website on Newtrient.com or other Newtrient online service does not mean that Newtrient endorses the site. Due to the nature of the World Wide Web, Newtrient cannot guarantee the quality or accuracy of information presented at every website link it provides or be responsible for the contents of non-Newtrient websites.
Information Protection
Newtrient takes precautions intended to help protect information that we collect and maintain. Unfortunately, however, no security measure is 100% secure. We cannot guarantee the security of information transmitted to or by us. Newtrient expects that you will use appropriate security measures to protect information you submit to us.
You are responsible for keeping confidential any log-in credentials, passwords or other forms of authentication involved in obtaining access to password-protected or secure areas of Newtrient.com or other online services. Access to any online services through your log-in credentials will be treated as authorized by you. Unauthorized access to password-protected areas of Newtrient’s online services is prohibited and may lead to criminal prosecution. We may suspend your use of all or part of any of the online services, without notice, if we suspect or detect any breach of security.
Geographic Restrictions
Newtrient is headquartered in the State of Illinois in the United States and the online services are controlled and operated from the United States. The online services are intended to provide for access and use only by persons located in the United States. You acknowledge that you may not be able to access the online services outside of the United States and such access may not be legal by certain persons or in certain countries. If you access the online services from outside the United States, you are responsible for compliance with all local laws.
We collect, process and store personal data in the United States, where privacy laws may not be as protective as in your place of residence. If you are using the online services from outside of the United States, by providing your personal data to us, you consent to the transfer of your personal data to the United States for processing consistent with these Terms.
The online services may be subject to US export control laws, including the US Export Administration Act and its associated regulations. You shall not, directly or indirectly, export, re-export or release Newtrient.com and other online services to, or make them accessible from, any jurisdiction or country to which export, re-export or release is prohibited by law, rule or regulation. You shall comply with all applicable federal laws, regulations and rules and complete all required undertakings, including obtaining any necessary export license or other governmental approval, prior to exporting, re-exporting, releasing or otherwise making Newtrient.com and other online services available outside the United States.
Please note: By agreeing to these Terms, you explicitly agree that any claims or actions that you may otherwise have against Newtrient under the laws of any jurisdiction outside the United States are hereby waived and that your sole location and applicable law for any dispute is in the United States according to the Dispute Resolution terms below.
Fair Use & Copyright Statement
This site may contain copyrighted material the use of which has not always been specifically authorized by the copyright owner. We are making such material available in an effort to advance understanding of environmental, political, human rights, economic, democracy, scientific, and social justice issues, etc. we believe this constitutes a ‘fair use’ of any such copyrighted material as provided for in section 107 of the US Copyright Law.
In accordance with Title 17 U.S.C. Section 107, the material on this site is distributed without profit to those who have expressed a prior interest in receiving the included information for research and educational purposes. For more information go to: http://www.law.cornell.edu/uscode/17/107.shtml
All vendor product and company names are trademarks™, registered trademarks® and/or trade names of the respective vendors or their licensors. Unless otherwise noted, Newtrient is not associated, connected or affiliated with, or sponsored or endorsed by, any vendor or licensor of such trademarks and trade names. If you wish to use copyrighted material from this site for purposes of your own that go beyond ‘fair use’, you must obtain permission from the copyright owner.
Intellectual Property Rights
The online services and included content (and any derivative works or enhancements of the same), including, but not limited to, all text, illustrations, files, images, software, scripts, graphics, photos, sounds, music, videos, information, content, materials, products, services, URLs, technology, documentation, and interactive features (collectively, the "content") and all intellectual property rights to the same are owned by Newtrient and/or our licensors, providers or suppliers. Additionally, all trademarks, service marks, trade names and trade dress that may appear on the online services are owned by us or our licensors, providers or suppliers. Except for the limited use rights granted to you in these Terms, you shall not acquire any right, title or interest in the online services or content. Any rights not expressly granted in these Terms are expressly reserved.
Use of Online Services
Access to the online services including, without limitation, the content of the online services is provided for your internal business or informational purposes only. When using the online services, you agree to comply with all applicable federal, state, and local laws including, without limitation, copyright law. Except as expressly permitted in these Terms, you may not use, reproduce, distribute, create derivative works based upon, publicly display, publicly perform, publish, transmit, or otherwise exploit the online services or their content for any purpose whatsoever without obtaining prior written consent from us or, in the case of third-party content, its respective owner. In certain instances, we may permit you to download or print content from the online services. In such a case, you may download or print (as applicable) one copy of such content for your personal, non-commercial use only. You acknowledge that you do not acquire any ownership rights by downloading or printing the online services or their content.
Furthermore, except as expressly permitted in these Terms, you may not:
i. remove, alter, cover, or distort any copyright, trademark, or other proprietary rights notice on the online services or their content;
ii. circumvent, disable or otherwise interfere with security-related features of the online services or their content including, without limitation, any features that prevent or restrict use or copying of any content or enforce limitations on the use of the online services or their content;
iii. use an automatic device (such as a robot or spider) or manual process to copy or "scrape" the online services or their content for any purpose without our express written permission. Notwithstanding the foregoing, we grant public search engine operators permission to use automatic devices (such as robots or spiders) to copy content from the online services for the sole purpose of creating (and only to the extent necessary to create) a searchable index of content that is available to the public. We reserve the right to revoke this permission (generally or specifically) at any time;
iv. collect or harvest any personal data from the online services or their content including, without limitation, user names, passwords, email addresses;
v. solicit other users to join or become members of any commercial online service or other organization without our prior written approval;
vi. attempt to or interfere with the proper working of the online services or their content or impair, overburden, or disable the same;
vii. decompile, reverse engineer, or disassemble any portion of any the online services or their content;
viii. use network-monitoring software to determine architecture of or extract usage data from the online services or their content;
ix. encourage conduct that violates any federal, state, or municipal laws, either civil or criminal, or impersonate another user, person, or entity without permission, etc.); or
x. engage in any conduct that restricts or inhibits any other user from using or enjoying the online services or their content.
You agree to fully cooperate with us to investigate any suspected or actual activity that is in breach of these Terms. When you provide us with information, you agree that you will maintain your information and ensure that it is always current, complete and accurate. If you provide untrue, incomplete or inaccurate information, you understand that we have the right to terminate your use of the online services.
Disclaimers
YOUR USE OF THE ONLINE SERVICES (INCLUDING, WITHOUT LIMITATION, ANY CONTENT) IS SOLELY AT YOUR OWN RISK. THE ONLINE SERVICES ARE PROVIDED "AS IS" WITHOUT WARRANTY OF ANY KIND. NEWTRIENT, ITS AFFILIATES, LICENSORS, PROVIDERS, SUPPLIERS, AGENTS AND CONTRACTORS DISCLAIM ALL WARRANTIES, EXPRESS OR IMPLIED, RELATED TO THE ONLINE SERVICES, INCLUDING THOSE OF MERCHANTABILITY AND FITNESS FOR A PARTICULAR PURPOSE.
Newtrient does not control or endorse, and is not responsible for, any service providers or other third parties. Without limiting the foregoing, Newtrient does not endorse and is not responsible or liable for any content, products or services available from or through any third parties identified or not identified through the online services. By using the online services, you agree that it is solely your responsibility to determine whether a third party or its content, product or service is accurate, useful, complete or appropriate for your business or other purposes. You must make your own independent judgement, and bear all risks associated with, your use of the online services, including, without limitation, its content.
Although we have attempted to provide accurate and objective reviews, information and other content on our online services, we have and assume no responsibility or liability for the content, including, without limitation, content that may contain errors, omissions, defamatory statements, misleading statements, personal data or confidential information. Newtrient does not guarantee the accuracy, integrity, quality or reliability of any content, including content provided by service providers, users of the online services or other third parties. Newtrient is not responsible for the reliability of the results that may be obtained from the use of the online services. In particular, we may not update Newtrient.com or other online service on a daily or other regular basis except as may be required by law. As such, the information and materials contained therein may be out of date or include omissions or other errors. We may change the information provided in our online services at any time without notice. Additionally, Newtrient's comments and opinions are based on the information available to Newtrient at the time of the review, because information provided by company's is always changing Newtrient uses what is available and this is not necessarily all the definitive evidence.
Limitation of Liability
Newtrient, its affiliates and collaborators shall not be liable for any indirect, special, punitive, consequential or incidental damages resulting from use of our online services or the materials, information, hyperlinks or other content contained in it, or on any other hyperlinked website, even if Newtrient, its affiliates or partners have been expressly advised of the possibility of such damages. You agree to hold Newtrient, its affiliates and partners harmless from and against any claims or actions based upon or related to the use of our website or any hyperlinked website.
IF FOR ANY REASON THE DISCLAIMERS OF WARRANTIES OR LIMITATIONS OF LIABILITY SET FORTH IN THIS SECTION IS/ARE INAPPLICABLE OR UNENFORCEABLE, THEN NEWTRIENT’S MAXIMUM LIABILITY FOR DAMAGES ARISING UNDER THESE TERMS IS THE LESSER OF (i) THE TOTAL FEES PAID BY YOU IN THE THREE (3) MONTH PERIOD PRECEDING YOUR CLAIM OR (ii) $100 USD.
The foregoing disclaimers and limitation of liability will not apply to the extent prohibited by applicable law. You acknowledge and agree that the above limitations of liability, together with the other provisions in these Terms that limit liability (when permitted by applicable law), are essential terms and that Newtrient would not be willing to grant you the rights set forth in these Terms but for your agreement to the above limitations of liability.
IF YOU ARE A CALIFORNIA RESIDENT, YOU WAIVE YOUR RIGHTS WITH RESPECT TO CALIFORNIA CIVIL CODE SECTION 1542, WHICH SAYS "A GENERAL RELEASE DOES NOT EXTEND TO CLAIMS WHICH THE CREDITOR DOES NOT KNOW OR SUSPECT TO EXIST IN HIS FAVOR AT THE TIME OF EXECUTING THE RELEASE, WHICH, IF KNOWN BY HIM MUST HAVE MATERIALLY AFFECTED HIS SETTLEMENT WITH THE DEBTOR."
Indemnification
You agree to defend, indemnify and hold harmless Newtrient from any and all losses, damages or other liability, claims, actions, judgments, settlements, interest, awards, penalties, fines, costs or expenses of any kind, including reasonable attorneys' fees and the costs of pursuing any insurance providers or enforcing any right to indemnification hereunder arising out of or related to your violation of these Terms or use or misuse of Newtrient’s online services. Newtrient reserves the right to assume the exclusive defense and control of any matter subject to indemnification hereunder. No settlement that affects the rights or obligations of Newtrient may be made without Newtrient’s prior written approval.
Dispute Resolution
These Terms shall be governed by and construed in accordance with the laws of the State of Illinois without giving effect to any principles of conflicts of law.
YOU AND NEWTRIENT AGREE THAT ALL CLAIMS WILL BE RESOLVED BY BINDING ARBITRATION IN THE MANNER SPECIFIED IN THIS SECTION AND THAT YOU AND NEWTRIENT WAIVE ANY RIGHT TO BRING SUCH CLAIMS BEFORE ANY COURT OF LAW. RIGHTS THAT YOU WOULD HAVE IF YOU WENT TO COURT, SUCH AS ACCESS TO DISCOVERY, MAY BE UNAVAILABLE OR LIMITED IN ARBITRATION. ANY CLAIM SHALL BE ARBITRATED ON AN INDIVIDUAL BASIS AND SHALL NOT BE CONSOLIDATED IN ANY ARBITRATION WITH ANY CLAIM OR CONTROVERSY OF ANY OTHER PARTY.
Any controversy, dispute or claim arising under or related to these Terms or your use of the online services will be resolved by binding arbitration by the American Arbitration Association ("AAA") in accordance with the AAA’s commercial rules of arbitration (the "AAA Rules"), rather than in court, except that (i) you may assert claims in small claims court in Chicago, Illinois, if your claims qualify for such a court and (ii) Newtrient and/or its licensors, suppliers and providers may bring actions in a court to enforce their respective intellectual property rights. The arbitration shall be conducted in Chicago, Illinois. The arbitrator shall be selected in accordance with the AAA Rules. Any award of the arbitrator shall be final and binding on each of the parties. The arbitrator shall not, however, have the power to award damages, the right to which each party hereby waives. The arbitrator will apply applicable law and the provisions of these Terms and the failure to do so shall be deemed an excess of arbitral authority and grounds for judicial review. The arbitrator’s decision must be with written explanation and remain confidential.
If any provision of the agreement to arbitrate in this Section is found unenforceable, the unenforceable provision shall be severed and the remaining arbitration terms shall be enforced (but in no case shall a class, representative or private attorney general arbitration be permitted). Regardless of any statute or law to the contrary, notice on any claim arising from or related to these Terms must be made within one (1) year after such claim arose or be forever barred. For purposes of this Section, these Terms and related transactions will be subject to and governed by the Federal Arbitration Act, 9 U.S.C. sec. 1-16.
Changes to the Terms
The Effective Date of these Terms is set forth at the top of this webpage. As we add new features, we may need to amend or supplement the Terms. If we amend these terms, we will post the revised Terms on this page with a new effective date. If we decide to use personal data in a manner that is materially different from the uses described in these Terms or otherwise disclosed to you, you will have the choice to allow or disallow any additional uses or disclosures of your personal data. Your continued use of our online services after the Effective Date constitutes your acceptance of the amended Terms, which supersede all previous versions of or agreements, notices or statements about the Terms.
Termination
Your right to access and use Newtrient.com or any other online service automatically terminates when you fail to comply with these Terms. Newtrient may terminate or modify your access to Newtrient.com or other online services, with or without notice and at any time for any reason. Termination shall not limit any of Newtrient’s other rights or remedies. Any provision that must survive in order to give proper effect to the intent and purpose of these Terms shall survive termination.
Miscellaneous Terms
These Terms contain the entire understanding by and between Newtrient and you with respect to the matters contained herein. These Terms inure to the benefit of and will be binding upon Newtrient’s and your successors and assigns, respectively. These Terms may be assigned by Newtrient but you may not assign these Terms without the prior express written consent of Newtrient. Nothing contained in these Terms will be deemed to constitute Newtrient or you as the agent or representative of the other or as joint venturers or partners. Headings and captions are for convenience only.
Contact Newtrient
If you have any queries or complaints about Newtrient's compliance with these Terms or if you would like to make any recommendations or comments to improve the quality of the Terms, please contact Newtrient:
Newtrient LLC
Attn: Newtrient
10255 West Higgins Road
Suite 900
Rosemont, IL 60018
[email protected]